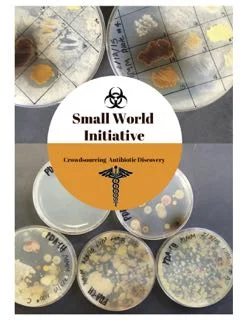

Winners of the SWI Art Contest
/Back in January, we started the SWI Art Contest to “crowdsource” illustrations for the design the cover of the Student Research Guide. The judges – some of our very own SWI leaders and partners – were amazed by the incredible talent of the participants and voted for the top art pieces. I am happy to announce the winners of the SWI Art Contest:
- 1st PLACE goes to Sarah Jeon from McGill University. Congratulations for designing the new cover of the Student Research Guide. Sarah’s work beautifully illustrates the name of our program and juxtaposes the different layers of our mission. Great job Sarah!
- 2nd PLACE goes to Yun Hsuan (Elena) Lin from McGill University, with a wonderful and surreal depiction of the research journey we embark on at the beginning of each semester.
- 3rd PLACE goes to Margaret Mass from University of Pittsburgh, which captures the methodology and observations that we are so dependent on for our research.
Sarah Jeon (1st place winner)
Elena Lin (2nd place)
Margaret Mass (3rd place)
- Honorary mention: Mitch Lambert from University of Northwestern – St. Paul, with a meticulous collage of lab supplies and equipment close-ups.
- Honorary mention: Natacha Maier from McGill University, which displays a fantastic “glow” of microbes living symbiotically in the soil.
- Honorary mention: Thu Truong from University of Pittsburg, with an impressive hand-drawn synopsis of our research project.
Mitch Lambert
Natacha Maier
Thu Truong
Congratulations to all of you on behalf of all the judges! Receiving and reviewing these art pieces was exciting for all of us and we thank you for sharing a piece of your imagination with the SWI community. These are truly imaginative, high-quality, and heartfelt works of art which will shape our vision of the program in years to come.